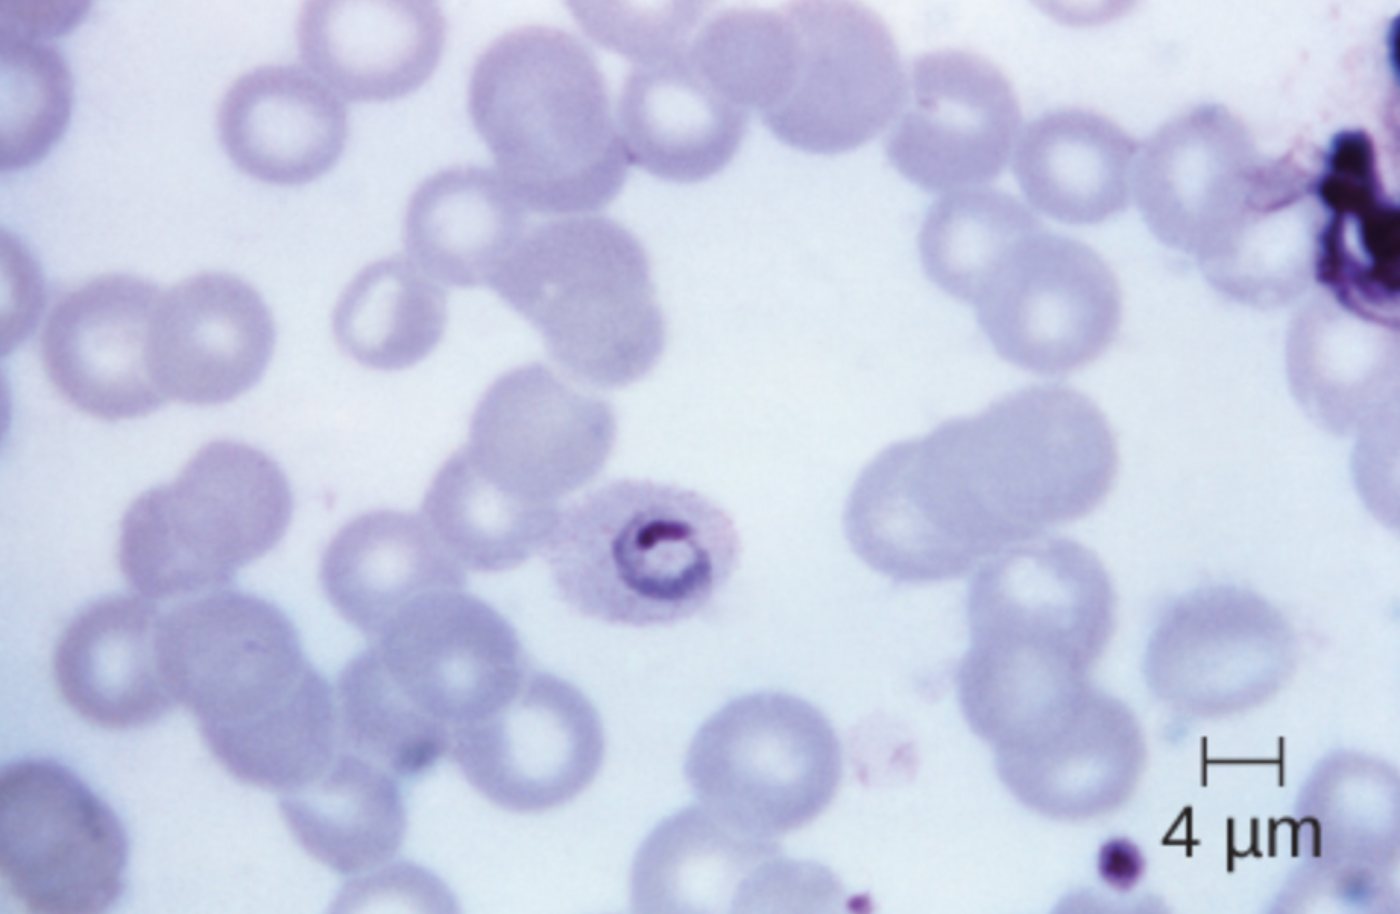
Diagnostic Identification of Ring-Shaped Plasmodium ovale in Malaria Blood Smears

The microscopic identification of Plasmodium ovale is a critical step in the diagnosis of malaria, particularly in identifying species that exhibit dormant liver stages. This guide explores the ring-shaped trophozoite morphology of P. ovale as seen on Giemsa-stained blood films, providing clinical insights into its lifecycle, anatomical presentation within erythrocytes, and the pathological impact on the human host.
4 μm: This scale bar provides a precise measurement indicating four micrometers in length at the current magnification. It serves as a diagnostic reference to estimate the diameter of the erythrocytes and the internal parasitic structures, helping clinicians distinguish Plasmodium ovale from larger or smaller species.
The Biological Profile of Plasmodium ovale
Eukaryotic cells exhibit a vast array of morphologies depending on their environment and functional requirements. In the case of the genus Plasmodium, these parasitic eukaryotes undergo dramatic structural changes as they transition through various stages of their complex lifecycle. Plasmodium ovale is one of the five species known to cause human malaria, primarily found in Sub-Saharan Africa and parts of the Western Pacific. It is a unique pathogen characterized by its ability to alter the shape of the host’s red blood cells, often causing them to appear elongated or “oval.”
The specific image provided displays the early trophozoite stage, commonly referred to as the “ring form.” During this phase, the parasite has recently entered the red blood cell and begins to consume hemoglobin. The “ring” is actually a thin circle of cytoplasm with a concentrated nucleus (chromatin dot), giving it the appearance of a piece of jewelry. This morphological stage is vital for diagnostic microscopy, as the density and appearance of these rings help laboratory technicians estimate the level of parasitemia in a patient.
Key clinical and anatomical features of P. ovale include:
- Infection primarily of young erythrocytes (reticulocytes).
- Production of Schüffner’s dots (fine stippling) on the host cell membrane.
- Enlargement and distortion of the red blood cell into an oval shape with fimbriated (jagged) edges.
- The formation of hypnozoites, which are dormant stages in the liver.
- Typically lower levels of parasitemia compared to P. falciparum.
The lifecycle of this eukaryote is divided between the Anopheles mosquito vector and the human host. Following a mosquito bite, sporozoites travel to the liver, where they mature and multiply. While most mature into merozoites that enter the bloodstream to cause symptomatic malaria, some P. ovale parasites enter a resting state. This ability to hibernate means that a patient can experience a relapse months or even years after the initial infection, even if they have left a malaria-endemic area.
Clinical Manifestations and Pathophysiology of Malaria
Malaria caused by P. ovale is generally considered less severe than the life-threatening infections caused by P. falciparum, yet it remains a significant medical concern due to its potential for relapse. The disease typically presents with “tertian” fever paroxysms, meaning the fever spikes occur every 48 hours, coinciding with the synchronized rupture of infected erythrocytes. Symptoms include high fever, rigors (shaking chills), profuse sweating, headache, and fatigue.
Physiologically, the parasite causes significant stress on the host’s circulatory system. As the parasites multiply within the erythrocytes, the cells lose their flexibility and are eventually destroyed. This leads to hemolytic anemia and splenomegaly (enlarged spleen) as the body attempts to filter out the damaged cells. In some cases, the immunological response to the parasite can cause systemic inflammation, contributing to the feeling of malaise and muscle aches reported by patients.
A unique challenge in treating P. ovale is the presence of hypnozoites. Standard antimalarial drugs that target the bloodstream phase of the parasite, such as chloroquine or artemisinin-based combination therapies (ACTs), do not affect the dormant liver stages. Therefore, to achieve a complete cure and prevent relapse, clinicians must prescribe “radical cure” medications, such as primaquine or tafenoquine. However, these drugs can cause severe hemolysis in patients with Glucose-6-Phosphate Dehydrogenase (G6PD) deficiency, making pre-treatment screening essential.
Microscopic Diagnosis and Anatomical Observations
The gold standard for diagnosing malaria remains the examination of thick and thin blood smears under a light microscope. As shown in the image, the thin smear allows for the detailed visualization of the parasite’s anatomy within the host cell. The scale bar indicating 4 μm is essential for the examiner, as a typical human red blood cell has a diameter of approximately 7 to 8 μm. This perspective allows the technician to confirm that the parasite occupies a specific portion of the intracellular space.
In P. ovale infections, the infected red blood cells are often slightly larger than neighboring uninfected cells. The “ring” itself may appear sturdier or thicker than the delicate rings of P. falciparum. As the parasite matures from the ring stage shown here into the schizont stage, it will fill more of the cell and eventually contain 6 to 14 merozoites arranged in an irregular cluster. Observing these specific morphological cues is what allows for species-level identification, which is critical for determining the correct course of treatment and assessing the risk of future relapse.
The study of Plasmodium ovale morphology provides a fascinating look into how parasitic eukaryotes adapt to a highly specialized niche within the human body. From the ring-shaped trophozoite to the dormant liver stages, every anatomical feature serves a purpose in the parasite’s survival and transmission. By maintaining high standards in microscopic diagnosis and understanding the physiological impact of the disease, healthcare providers can effectively manage malaria and reduce the global burden of this persistent tropical illness.

